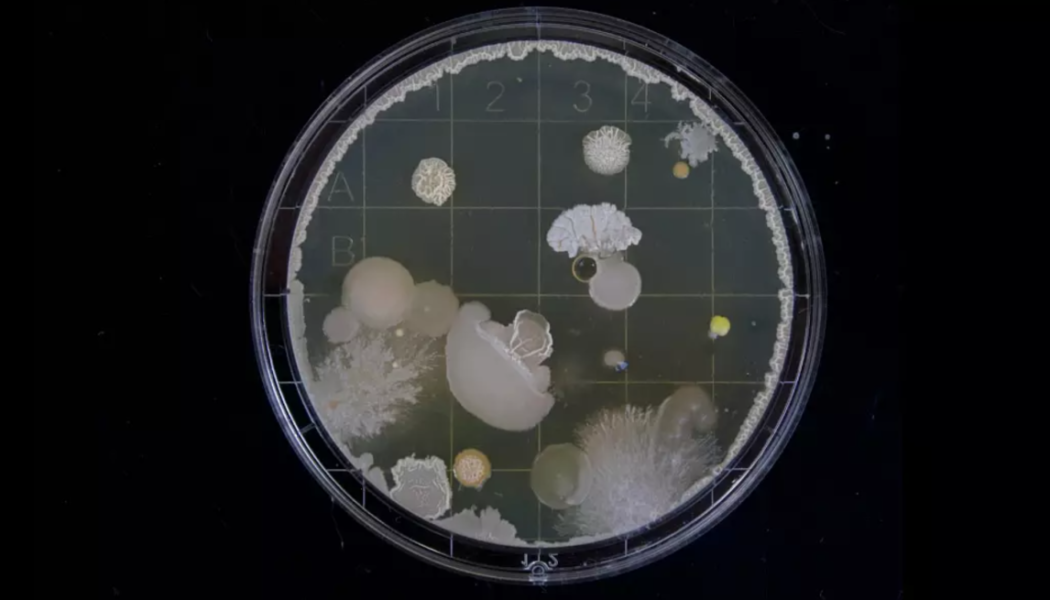
Biologist Music Producer Creates First Living Record With Yeast Cells

He’s a biomedical researcher, touring artist, and he’s created the first living record.
Indeed, Mikael Hwang is a man of many talents, and his appreciation for the arts and sciences are inextricably linked. Released via Universal Music, Hwang’s recent Signal EP and its accompanying art installation have demonstrated that even microscopic multicellular organisms—in this case, yeast cells—are capable of producing music.
Debuting at South Korea’s Paradise Art Lab Festival 2022, the “Signal” installation aimed in part to show viewers that the future of music may well be biologically driven.
A special hybridized petri dish and record setup was embedded in an obelisk at the center of the exhibit. Inside was a proprietary substance that facilitated the capture of the yeast cell vibrations, allowing them to effectively be transmitted into playable audio.
Scroll to Continue
Recommended Articles
“Music, of course, is the focus but creating a space for people to experience what it could sound like, and what the future of music could be if it were biological was what I ultimately wanted to convey with this work,” said Hwang in a statement.
With intentions to create a fully living instrument down the line, Hwang continues to be eager to explore what he believes is a paradigm shift in the relationship between biology, culture and the arts.
“In the future, culture, whether in the form of music, text, or moving images, will likely be battlegrounds for propaganda and countercultural narratives,” Hwang added. “‘Signal,’ and the likes, will hopefully invite timely discussions and scrutiny, preparing us with a language that can help us express and understand the new relationships and definitions we’ll have with life.”
 [flexi-common-toolbar] [flexi-form class=”flexi_form_style” title=”Submit to Flexi” name=”my_form” ajax=”true”][flexi-form-tag type=”post_title” class=”fl-input” title=”Title” value=”” required=”true”][flexi-form-tag type=”category” title=”Select category”][flexi-form-tag type=”tag” title=”Insert tag”][flexi-form-tag type=”article” class=”fl-textarea” title=”Description” ][flexi-form-tag type=”file” title=”Select file” required=”true”][flexi-form-tag type=”submit” name=”submit” value=”Submit Now”] [/flexi-form]
[flexi-common-toolbar] [flexi-form class=”flexi_form_style” title=”Submit to Flexi” name=”my_form” ajax=”true”][flexi-form-tag type=”post_title” class=”fl-input” title=”Title” value=”” required=”true”][flexi-form-tag type=”category” title=”Select category”][flexi-form-tag type=”tag” title=”Insert tag”][flexi-form-tag type=”article” class=”fl-textarea” title=”Description” ][flexi-form-tag type=”file” title=”Select file” required=”true”][flexi-form-tag type=”submit” name=”submit” value=”Submit Now”] [/flexi-form]

Tagged: entertainment blog, LIFESTYLE, music blog